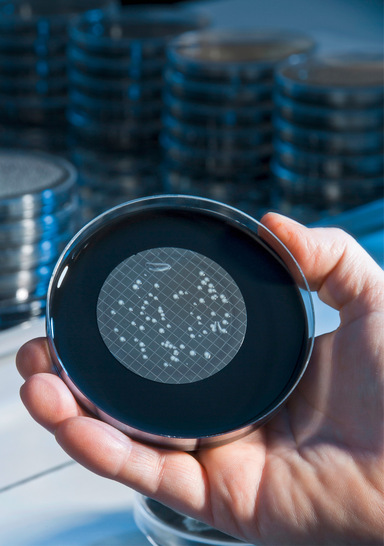

Die neue UBA-Empfehlung „Systemische Untersuchungen von Trinkwasserinstallationen auf Legionellen nach Trinkwasserverordnung – Probennahme, Untersuchungsgang und Angabe des Ergebnisses“ vom 13. Oktober 2025 „dient der Festlegung und Beschreibung des Vorgehens bei der systemischen Untersuchung auf Legionellen nach § 31 der Trinkwasserverordnung (TrinkwV) und beschreibt die Probennahme, den Untersuchungsgang und die Angabe des Ergebnisses“. Sie ist damit die einzige verbindliche Vorgehensweise, wenn es um die Erfüllung dieses Paragrafen der TrinkwV geht.
Über die TrinkwV hinaus gibt es jedoch weitere Rechtspflichten, je nach Art der Nutzung der Gebäude. Dazu gehören vor allem die Verkehrssicherungspflicht und/oder die Technische Regel für Arbeitsstätten „Gefährdungsbeurteilung“ (ASR V3). Auf dieser Basis sind zusätzliche Untersuchungen auf Legionellen auch in der Peripherie von Trinkwasser-Installationen durchzuführen, die als weitergehende Untersuchungen bezeichnet werden. Warum sie von Bedeutung sind, erläutert Rechtsanwalt Hartmut Hardt, dessen juristischer Schwerpunkt auf dem Betreiberrecht liegt, in einem ergänzenden Interview.
→ Interview: „Die TrinkwV ist ein wichtiger, aber nicht abschließender Maßstab“
Zirkulierendes Warmwasser im Fokus
Die aktualisierte Empfehlung des UBA definiert das Ziel einer systemischen Untersuchung enger als bisher, indem sie vorgibt: „Ziel der systemischen Untersuchung ist die Überprüfung, ob Legionellen in einer relevanten Konzentration im zirkulierenden Trinkwasser warm vorkommen.“ Weiter heißt es: „In der Peripherie sind die Probennahmestellen so zu wählen, dass sie mit möglichst kurzer Anschlussleitung an das Ende der Steigstränge angebunden sind. Bei Horizontalverteilungen ist äquivalent zu verfahren.“
Damit ist jedoch nicht gemeint, dass bei einer Probennahme das zu untersuchende Trinkwasser direkt über ein Probennahmeventil aus dem zirkulierenden Warmwasser entnommen werden darf, beispielsweise am Fußpunkt einer Zirkulation. Zu beproben ist vielmehr das Trinkwasser aus dem längsten Fließweg an der nächstgelegenen Entnahmestelle mit regelmäßiger Nutzung. Dort darf bzw. – je nach Art der Armatur – muss ein Probennahmeventil am Eckventil zur Entnahme des Trinkwassers verwendet werden.
Demnach erfüllt die bisherige orientierende Untersuchung nach DVGW-Arbeitsblatt W 551, bei der das Trinkwasser am Ende einer Stichleitung entnommen wurde, nicht mehr § 31 TrinkwV. Diese peripheren Entnahmestellen werden jedoch zur Erfüllung anderer Rechtspflichten für weitergehende Untersuchungen weiterhin benötigt. Sie bilden sozusagen ein „Worst-Case-Szenario“ ab, nämlich den Verbraucherschutz im längsten Fließweg von Stichleitungen, und müssen nun zusätzlich beauftragt werden.
Verlegung von Probennahmestellen?
Um den Untersuchungsauftrag auf Legionellen gemäß § 31 TrinkwV zu erfüllen, muss jetzt anhand eines Strangplanes o. Ä. überprüft werden, welche reguläre Entnahmestelle möglichst nah am längsten Fließweg des Warmwassers liegt, bevor die Zirkulationsleitung beginnt.
Festgelegt ist, dass es sich um eine Entnahmestelle handeln muss, für die der bestimmungsgemäße Betrieb sichergestellt ist. Und je nach Art der Entnahmestelle, wird „dem Betreiber [...] empfohlen, gut erreichbare Eckventile gegebenenfalls mit Probennahmearmaturen zu installieren“.
Was bleibt wie bisher?
Die Untersuchungspflicht für Großanlagen (vgl. DVGW-Arbeitsblatt W 551) bei Vernebelung von Warmwasser bleibt erhalten. Weiterhin erhalten bleiben die Probennahmestellen am Abgang des Trinkwassererwärmers und im Rücklauf der Zirkulation. Wie bisher ist zusätzlich „jeder Steigstrang in die Untersuchungen einzubeziehen. Dies bedeutet nicht zwingend, dass Proben aus allen Steigsträngen zu entnehmen sind.“
Sie müssen jedoch repräsentativ für die anderen Steigstränge sein. „Die Auswahl ist zu dokumentieren [...] und zu begründen. Die Begründung ist vom Betreiber auf Verlangen dem Gesundheitsamt vorzulegen.“
Begründung für die neue systemische Untersuchung
Der Gesetzgeber möchte sich bei der zukünftigen Überwachungspflicht auf Legionellen gemäß § 31 TrinkwV auf zentrale Bereiche der Trinkwasser-Installation – wie Trinkwassererwärmer, Verteiler, Steigstränge oder Zirkulationsleitungen – fokussieren, weil sich eine mögliche Kontamination mit Legionellen in diesen Bereichen „auf die Trinkwasserqualität an einer größeren Anzahl von Entnahmestellen auswirken“ kann.
Warum sollen lokale Kontaminationen nicht mehr erfasst werden?
Eine weitere Begründung für die Einengung der TrinkwV auf systemische Untersuchungen findet sich im Abschnitt 2.3 „Lokale Kontamination“. Dort steht: „Eine lokale Kontamination bezieht sich auf eine einzelne Entnahmearmatur (z. B. eine Waschtischarmatur, einen Duschkopf oder einen Duschschlauch). Der Einfluss einer lokalen Kontamination auf benachbarte Entnahmearmaturen oder Teile der Trinkwasserinstallation ist begrenzt. Darüber hinaus stehen lokale Kontaminationen im Gegensatz zu systemischen Kontaminationen in der Regel in engem Zusammenhang mit dem Nutzerverhalten hinsichtlich der Trinkwasserentnahme an den peripheren Entnahmestellen.“
Ist die Erfassung lokaler Kontamination weiterhin sinnvoll/notwendig?
Die Legionelle weiß nicht, wo sie sich in der Trinkwasser-Installation befindet! Es ist also nachvollziehbar, dass mögliche Gesundheitsgefährdungen unabhängig von der rechtlichen Festlegung der Untersuchungsstellen gemäß TrinkwV entstehen können. Daher können aus Gründen der Verkehrssicherungspflicht oder der ASR V3 zusätzliche Entnahmestellen sinnvoll sein, nämlich in der Peripherie von Stichleitungen.
Hier erfolgen dann weitergehende Untersuchungen, zumal weiterhin an jeder Entnahmestelle (§ 10 TrinkwV) in einem Gebäude die mikrobiologischen und chemischen Anforderungen eingehalten werden müssen, also auch der Parameter Legionella spec. in der Peripherie von Stichleitungen.
Wann tritt die neue Vorgehensweise in Kraft?
Bevor die Änderungen rechtliche Verbindlichkeit erlangen, muss die TrinkwV angepasst werden. Dies setzt auch die Verabschiedung der geänderten Version im Bundesrat voraus. Geplant war dies für das 2. Quartal 2026, was jedoch nach heutigem Kenntnisstand kaum noch gelingen wird.
Fazit
Betreiber, Fachplaner, Fachhandwerker, Labore und Sachverständige sollten sich bis zum Erscheinen der geänderten TrinkwV irgendwann im Jahr 2026 auf die neuen Vorgaben einstellen. Es wäre jedoch aufgrund weiterer Rechtspflichten zu kurz gesprungen, auf die zusätzliche Beprobung bewährter Entnahmestellen in der Peripherie zu verzichten. Daher kommt nach wie vor den weitergehenden Untersuchungen aus dem DVGW-Arbeitsblatt W 551 eine hohe Bedeutung zu.
Zukünftig aber aus drei Gründen: erstens für den unmittelbaren Verbraucherschutz aufgrund weiterer Rechtspflichten neben der TrinkwV, zweitens für eine intensivere Beprobung der Trinkwasser-Installation bei Erreichen des technischen Maßnahmenwertes und drittens für den Gesundheitsbereich. Denn im Gesundheitsbereich bleibt alles beim Alten: Dort gibt es nur die weitergehende und nicht die systemische Untersuchung nach TrinkwV (siehe UBA-Empfehlung „Periodische Untersuchung auf Legionellen in […]“ aus dem Jahr 2006).
- Künftig setzt die neue UBA‑Empfehlung vom 13. Oktober 2025 den verbindlichen Rahmen für die systemische Untersuchung auf Legionellen nach § 31 TrinkwV.
- Die UBA-Empfehlung tritt voraussichtlich durch eine Änderung der TrinkwV irgendwann noch 2026 in Kraft.
- Aufgrund des Vorlaufs bei Planung, Installation und Beauftragung kann die UBA‑Empfehlung schon vor ihrem Inkrafttreten für Betreiber, Fachplaner, Fachhandwerker und Labore Relevanz haben.
- Für Gesundheitseinrichtungen bleibt alles beim Alten: Die systemische Untersuchung nach TrinkwV entspricht weiterhin der weitergehenden Untersuchung nach DVGW-Arbeitsblatt W 551.
![Je nach Art der Entnahmestelle wird in der UBA-Empfehlung „dem Betreiber [...] empfohlen, gut erreichbare Eckventile ggf. mit Probennahmearmaturen zu installieren“.](/sites/default/files/styles/aurora_default/public/aurora/2026/04/530995.jpeg?itok=VMaol5v8)
Bild: Schell

Bild: Schell / verändert nach DVGW-Arbeitsblatt W 551
Weitere Infos auf www.sbz-online.de
Neugierig geworden?
Mehr Beiträge zum Thema Trinkwasserhygiene finden Sie in unserem Online-Dossier unter: